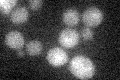
YOR087W
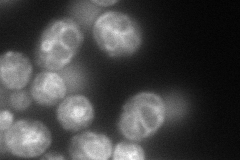
YOR087W
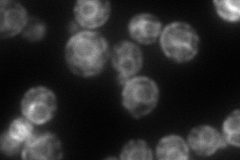
YOR087W
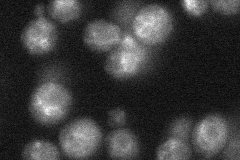
YOR087W
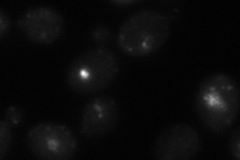
YOR087W
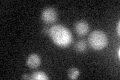
YOR087W

View description
Vacuolar cation channel, mediates release of Ca(2+) from the vacuole in response to hyperosmotic shock
Localization:
Intensity:
Fold change:
Significance:
-
C’ GFP library in SD
below threshold16.13 -
N' NOP1pr-GFP in SD
vacuole membrane156.133 -
N' TEF2pr-mCherry in SD
ER,vacuole121.251 -
N' NATIVEpr-GFP in SD
vacuole membrane35.3689 -
N' TEF2pr-VC and Cyto-VN in SD
punctate36.7551 -
C’ GFP library in SD+DTT
cytosol18.151.12No -
C’ GFP library in SD+H2O2

cytosol16.431.01No -
C’ GFP library in Starvation Media

cytosol16.411.01No -
C’ GFP library on the background of Pup2-DaMP

below threshold -
C’ GFP library on the background of CCT mutant

below threshold17.00361.05374No
